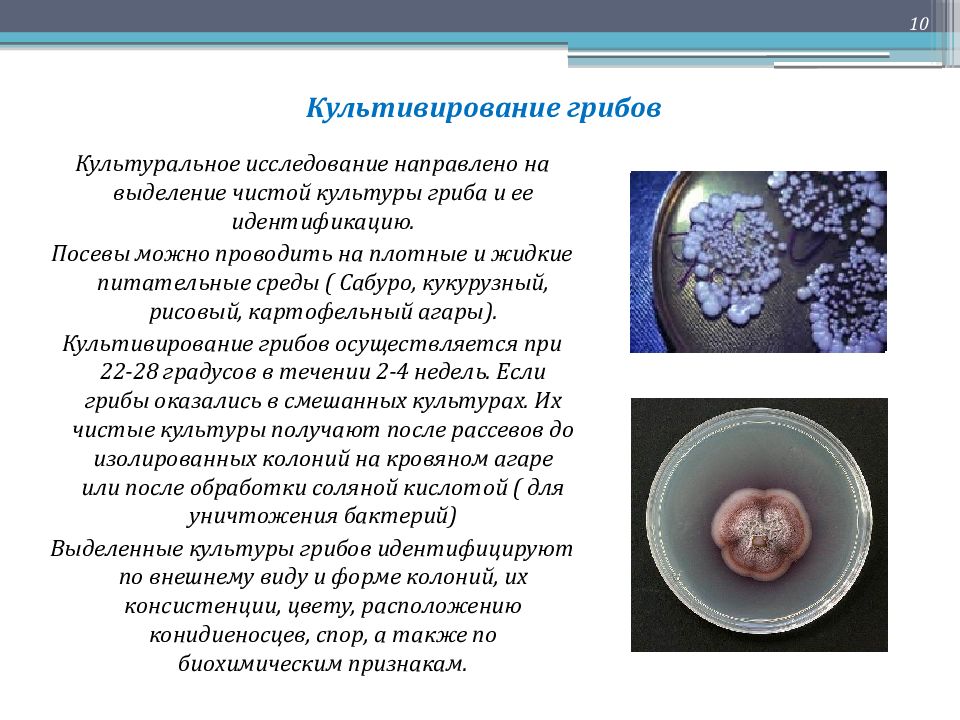

Генетический материал грибы
Парк сказка какое метро
Причины пожаров в жилых помещениях
Новый русский стиль 2025
Медные трубки 20 мм
Педагогический колледж факультеты и специальности
Новая версия старых песен
Замена нижней шаровой хонда аккорд
Болезни перцев фото листьев
Фран 1 элжур
Каталог мир кашемир
Это бруклин vakho текст
Битрикс настройка уведомлений
Велосипед навигатор 7 скоростей
Генетический материал грибы 108 фотографий